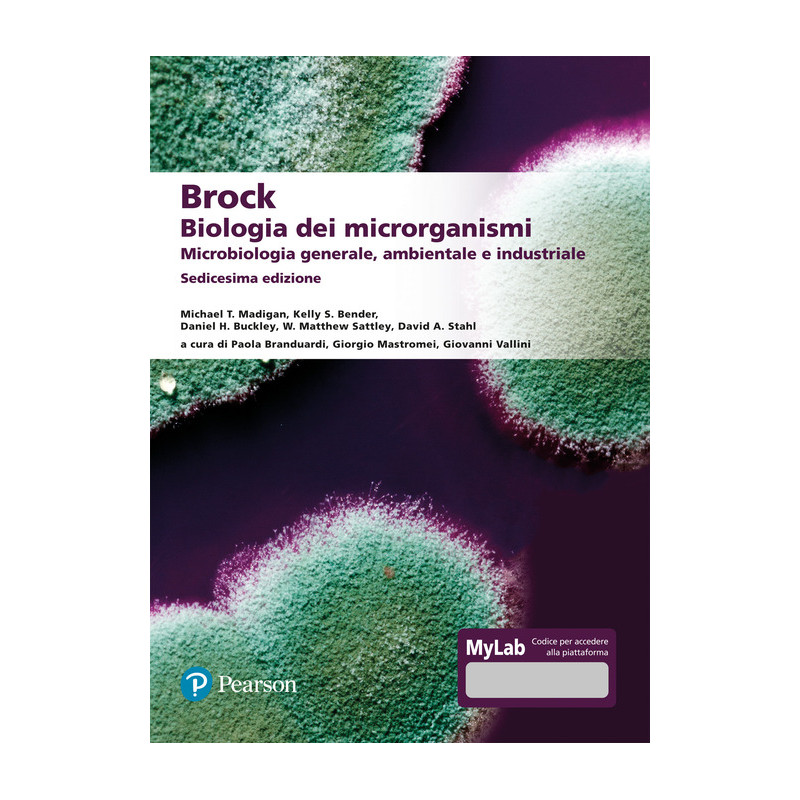

Brock. Biologia dei microrganismi. Microbiologia generale, ambientale e industriale. Ediz. Mylab. Con aggiornamento online
- Anno Edizione......: 2022
- EAN.........................: 9788891906298
- Editore....................: Pearson
- Collana...................: Scienze
- Pagine.....................: 924
70,00 €
Tasse incluse
L'attività didattica e di apprendimento del corso è proposta all'interno di un ambiente digitale per lo studio, che ha l'obiettivo di completare il libro offrendo risorse didattiche fruibili in modo autonomo o per assegnazione del docente. Il codice presente sulla copertina di questo libro consente l'accesso per 18 mesi a MyLab, una piattaforma digitale interattiva specificamente pensata per accompagnare e verificare i progressi durante lo studio. MyLab offre la possibilità di accedere al manuale online: l'edizione digitale del testo arricchita da funzionalità che permettono di personalizzarne la fruizione, attivare la lettura audio digitalizzata, inserire segnalibri anche su tablet e smartphone.
Commenti Nessun cliente per il momento.